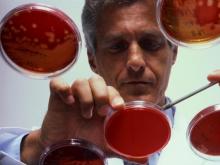
Продавца индийского препарата для лечения рака крови сняли с конкурса по правилу «Третий лишний»

Директоры предприятий ответили на вопросы о счетчиках электроэнергии и многолетних цветах
Рекомендации депутата Васева платить из городского бюджета "Горсвету" за освещение улиц не "столбам" или по заявленной мощности, а установить счетчики электроэнергии, уже не актуальны. Где-то неточен оказался, а где-то опять-таки запоздал депутат и с замечаниями в адрес "Горзеленхоза".
Пешеходам на перекрестке оставили 25 секунд. ГИБДД: «Мы выбрали из двух зол меньшее»
Сотрудники челнинской госавтоинспекции изучили интенсивность движения на перекрестке проспектов Сююмбике — Автозаводский и решили, что не будут менять режим работы светофоров в пользу пешеходов, так как иначе возникнут дорожные заторы.
Куда уходят доходы от сдачи в аренду земель в национальном парке?
Тот факт, что администрация Национального парка "Нижняя Кама" вынуждена изыскивать деньги на оплату транспортировки мусора, собранного добровольцами в лесу, удивил одного из читателей "Челны ЛТД". "Полпарка отдано в аренду, а денег нет?" - ехидно спрашивал он.
На "неразрешенном" пляже на улице Центральная все равно поставят спасателей
Купаться в городе Набережные Челны официально разрешено в трех местах, ставить лодки - на четырех базах отдыха. Но власти понимают, что в летнюю жару челнинцы лезут в воду еще как минимум в семи точках. Но оберегать их жизнь и здоровье решили только в одной из них. Во всех остальных местах повесят предупреждающие знаки...